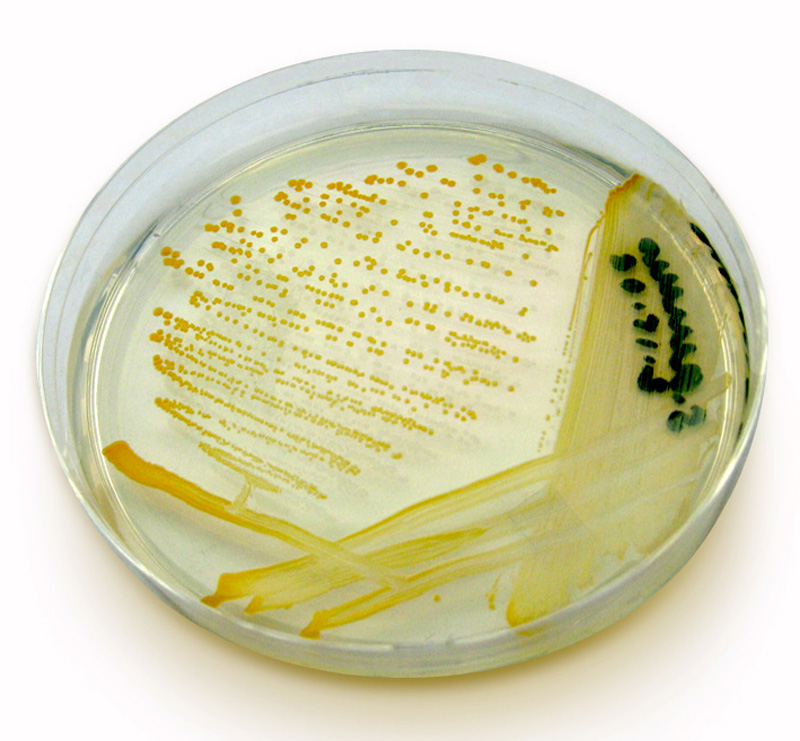

Covid-19 Worldwide Analysis
Analyzed trends revolving around COVID-19 vaccinations and deaths from January 2020 to April 2021 at the peak of the lockdown period. This project is based around SQL for data manipulation and Tableau for visualization.

Analyzed trends revolving around COVID-19 vaccinations and deaths from January 2020 to April 2021 at the peak of the lockdown period. This project is based around SQL for data manipulation and Tableau for visualization.
This project is based around air contamination tests performed in the workplace. Air tests use media plates placed in different areas of the production facility to see what aerial microbes are sources for potiential contamination of wild yeast cultures. This project utilizes SQL for data collection/cleaning as well as Tableau for visualization.
My background is based in Microbiolgy and Data Analysis with my college coursework emphasizing in Ecology and Bioconservation as well.
I have worked in the food science sector for 2 years where I perform quality control measures on yeast cultures. Most of my work is related to Microbiology and looking at characteristics of yeast samples such as cell viabilty using Hemocytometry, qt-PCR, refractometry, light miscroscopy, and pH meter measurments before yeast cultures are shipped to customers.
I worked in the food service industry for 5 years in which I held the team lead role for the last year and a half. Much of my work went into training kitchen staff on proper procedures while emphasizing sanitziation and saftey when applicable. I helped manange small teams through shifts that were typically high in sales volumne.
Both of my longest held positions are team-based where communication between departments or stations is essiential to proper shift functionality. I am adaptable and try to be a team player, being adjustable to the needs of my peers.
In my recent college and job endeavors, I have developed a passion for working wth data through various mediums. I am striving to become a data analyst by learning programs, such as SQL and Tableau, and applying these skills to improve the workflow in my current occupation.
I am always looking for new opportunites to improve my current skillset while also developing new skills along the way. The best way to reach me is through email.